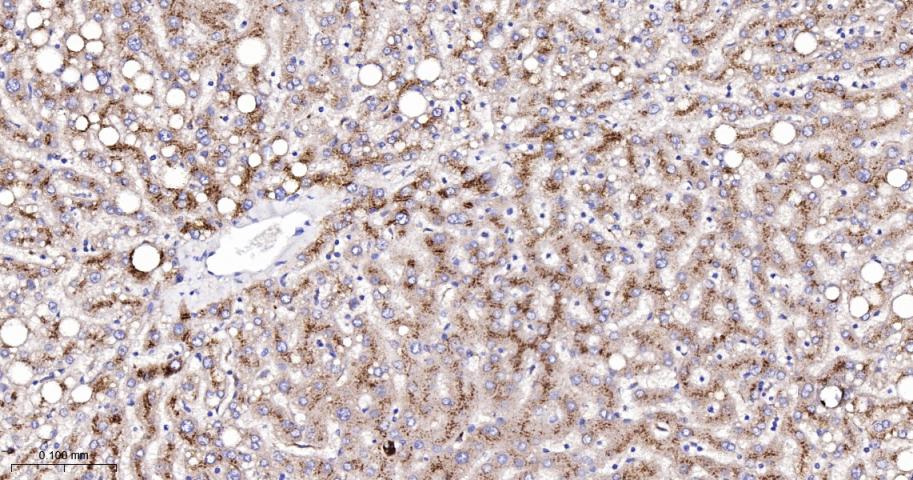
肉毒碱棕榈酰基转移酶2重组兔单抗
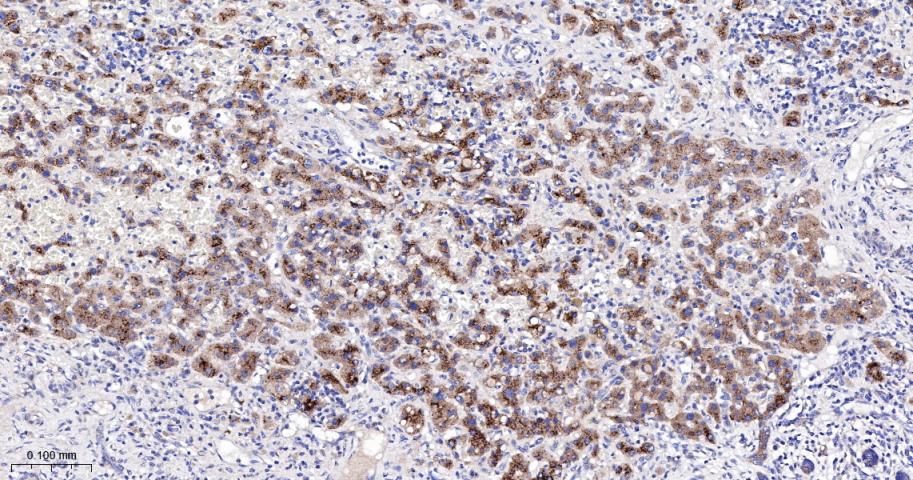
肉毒碱棕榈酰基转移酶2重组兔单抗
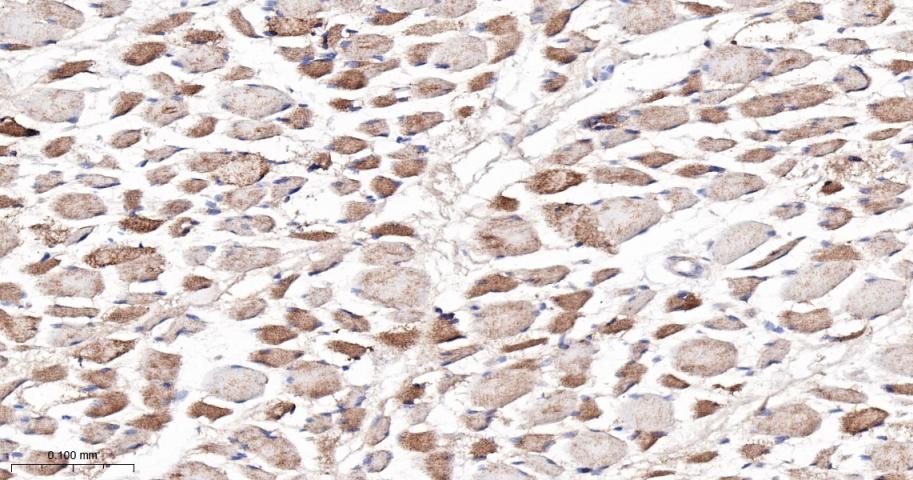
肉毒碱棕榈酰基转移酶2重组兔单抗
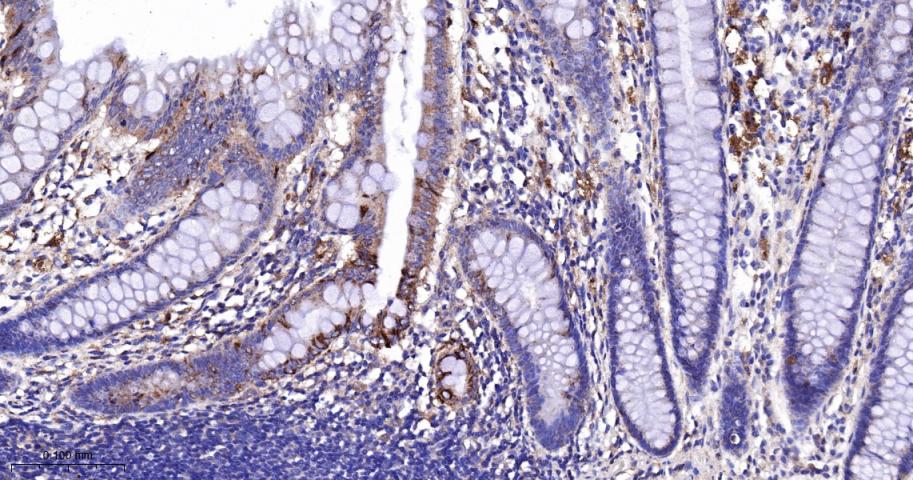
肉毒碱棕榈酰基转移酶2重组兔单抗

CPT2 Recombinant Rabbit mAb (一抗) - WB,IHC-P,IHC-F,IF,ICC/IF | Bioss

概述
Cancer > Cancer Metabolism > Metabolic signaling pathway > Metabolism of lipids and lipoproteins
Cardiovascular > Lipids / Lipoproteins > Fatty Acids > Metabolism
Metabolism > Pathways and Processes > Metabolic signaling pathways > Lipid and lipoprotein metabolism > Fatty acids
Metabolism > Pathways and Processes > Metabolic signaling pathways > Lipid and lipoprotein metabolism > Lipid metabolism
Metabolism > Pathways and Processes > Mitochondrial Metabolism > Mitochondrial markers
Metabolism > Pathways and Processes > Redox metabolism > Fatty acid oxidation
Signal Transduction > Metabolism > Lipid metabolism
Signal Transduction > Metabolism > Mitochondrial
Tags & Cell Markers > Subcellular Markers > Organelles > Mitochondria

产品应用
| 应用 | 已检合格种属 | 预测种属 | 推荐稀释比例 |
|---|---|---|---|
| WB | Human, Mouse, Rat | 1:500-2000 | |
| IHC-P | Human, Mouse | Rat | 1:50-200 |
| IHC-F | Human, Mouse | Rat | 1:50-200 |
| IF | Human, Mouse | Rat | 1:50-200 |
| ICC/IF | Human, Mouse, Rat | 1:50-200 |
交叉反应
交叉反应: Human, Mouse, Rat
相关产品
暂无相关产品
靶标
Carnitine palmitoyltransferase 2 deficiency infantile (CPT2DI) [MIM:600649]: A disorder of mitochondrial long-chain fatty acid oxidation characterized by hepatic or hepato-cardio-muscular manifestations with onset in infancy. Clinical features include hypoketotic hypoglycemia, lethargy, seizures, hepatomegaly, liver dysfunction, cardiomegaly and dilated cardiomyopathy. Note=The disease is caused by mutations affecting the gene represented in this entry.
Carnitine palmitoyltransferase 2 deficiency lethal neonatal (CPT2D-LN) [MIM:608836]: Lethal neonatal form of CPT2D. This rarely presentation is antenatal with cerebral periventricular cysts and cystic dysplastic kidneys. The clinical variability of the disease is likely attributed to the variable residual enzymatic activity. Note=The disease is caused by mutations affecting the gene represented in this entry.
Encephalopathy, acute, infection-induced, 4 (IIAE4) [MIM:614212]: A severe neurologic complication of an infection. It manifests within days in otherwise healthy children after common viral infections, without evidence of viral infection of the brain or inflammatory cell infiltration. In affected children, high-grade fever is accompanied within 12 to 48 hours by febrile convulsions, often leading to coma, multiple-organ failure, brain edema, and high morbidity and mortality. The infections are usually viral, particularly influenza, although other viruses and even mycoplasma have been found to cause the disorder. Note=Disease susceptibility is associated with variations affecting the gene represented in this entry. CPT2 polymorphic variants do not cause classical carnitine palmitoyltransferase 2 deficiency, and patients harboring any of them are asymptomatic most of the time. However, they are prone to viral infection (high fever)-related encephalopathy (PubMed:21697855).